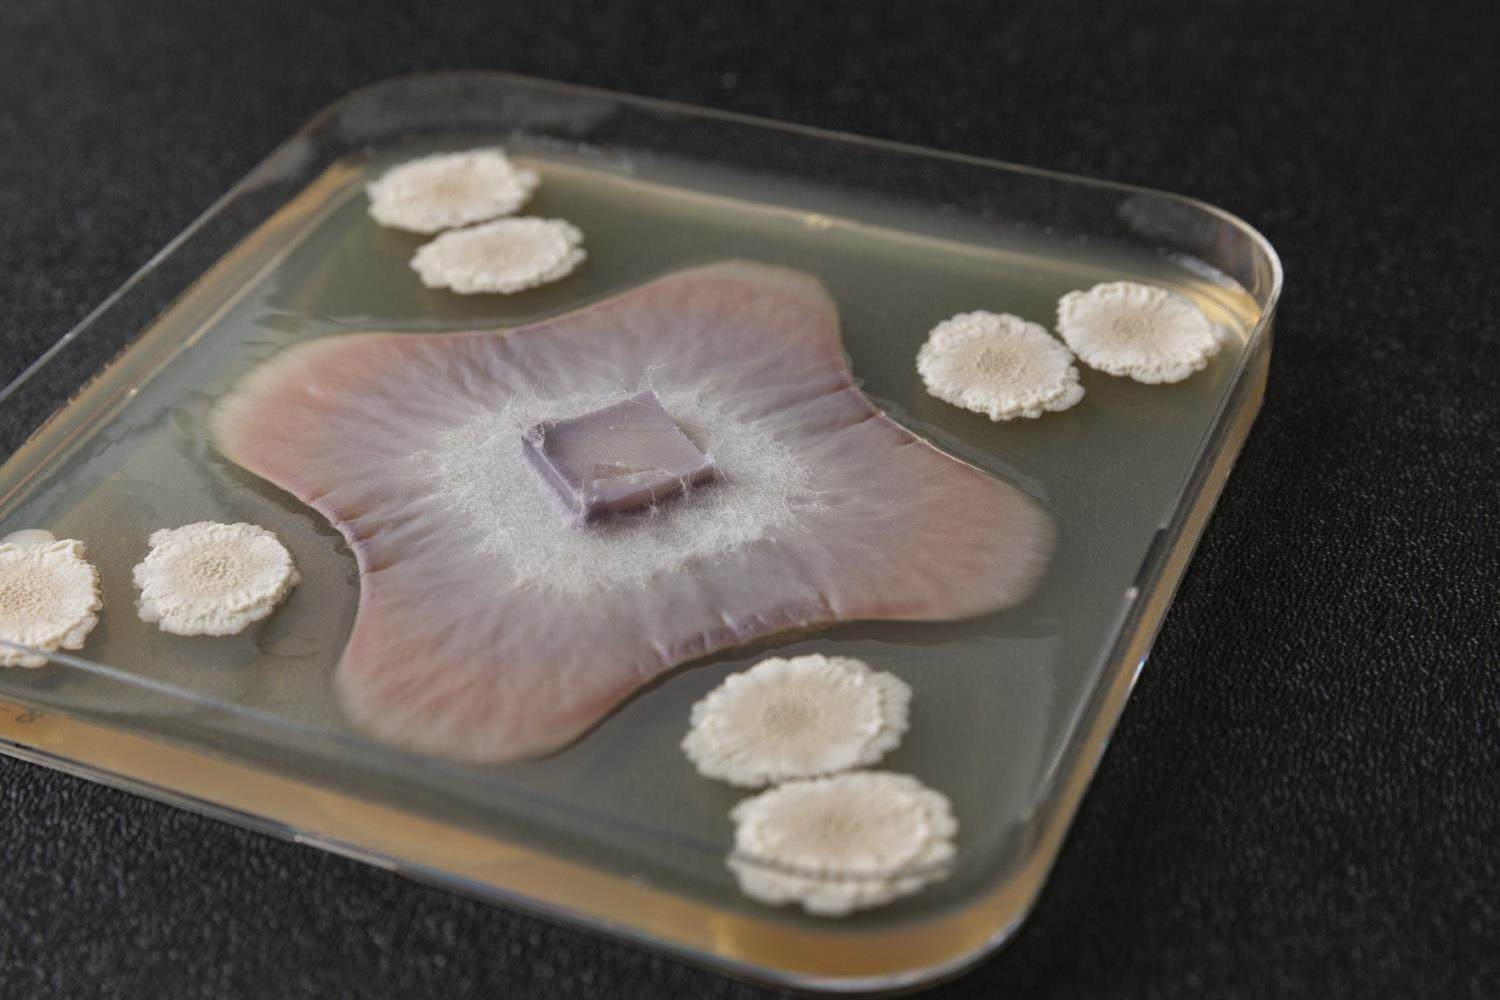

3 manieren om microben op het juiste moment op de juiste plek te krijgen
U kent ongetwijfeld de uitdrukking "op het juiste moment op de juiste plaats zijn". In dit artikel richt ik me op de juiste plaats. Hoe krijg je microben op de juiste plek en wat is eigenlijk de juiste plek? Voor veel microben is de juiste plaats in of rond het wortelstelsel van planten. Er bestaan verschillende toepassingsmethoden om de microben in de buurt van zaden en planten te krijgen, zoals bladtoepassing, toepassing in de grond en toepassing op zaden. Hoe werken deze methoden en welke voordelen en beperkingen hebben ze?
Voor veel microben is de plaats waar ze moeten zijn het wortelstelsel van planten.
1. Bladtoepassing
Bladtoepassing is een techniek waarbij planten worden behandeld door vloeibare meststoffen, onder andere, direct op de bladeren te spuiten. Naast meststoffen kunnen ook andere stoffen zoals gewasbeschermingsmiddelen en micro-orgaismenmet deze techniek worden toegepast. De vloeistof wordt opgenomen via de huidmondjes en de opperhuid van het blad.
Een belangrijke factor bij bladbemesting is het weer. Regen kan de aangebrachte producten wegspoelen en warme temperaturen kunnen ertoe leiden dat de plant zijn poriën sluit, waardoor de stoffen niet kunnen worden opgenomen. Ook is het belangrijk dat de bladeren niet te lang nat blijven, omdat dit soms ongedierte en schimmels kan aantrekken.
Als microben actief moeten zijn in het wortelstelsel, is bladtoepassing wellicht niet de beste keuze. Micro-organismen die actief zijn in de bladeren, kunnen via deze methode worden toegepast, als de bladeren de micro-organismen kunnen opnemen. Maar bladtoepassing kan alleen plaatsvinden als de bladeren enkele weken oud zijn, zodat er voldoende bladoppervlak is.
2. Toepassing in de grond
In furrow betekent dat het product samen met het zaad in de grond wordt aangebracht. Deze methode kan worden gebruikt voor onder meer meststoffen, micronutriënten, fungiciden en micro-organismen. De producten kunnen zowel vloeibaar als in poedervorm/korrels worden toegepast.
Bij in-furrow toepassing worden de micro-organismen rechtstreeks in de grond gebracht, maar niet altijd direct naast de zaden. Dit kan betekenen dat als er ziekteverwekkers in de grond zitten, de ziekteverwekkers de zaden kunnen infecteren voordat de nuttige micro-organismen de kans krijgen om het zaad en/of de wortels te koloniseren.
3. Toepassing op het zaad
Zaadcoating is het aanbrengen van materialen op het oppervlak van zaden om de vorm, de grootte en het oppervlak van het zaad uniformer te maken. Deze technologie vergemakkelijkt het plantproces en maakt het mogelijk producten aan te brengen die de zaadkwaliteit verbeteren en bescherming bieden tegen (a)biotische stress. De producten worden rechtstreeks op het zaad aangebracht, zodat de producten zich bij het ontkiemen meteen ter plaatse bevinden.
Veel micro-organismen zijn actief in het wortelsysteem van de plant, waar ze helpen bij de opname van voedingsstoffen of de bestrijding van bodempathogenen of insecten. Door toepassing op zaad kunnen de micro-organismen meegroeien en zich ontwikkelen met de opkomende wortel en deze zo snel mogelijk koloniseren, zodat andere micro-organismen zoals bodempathogenen dit niet kunnen doen.
Door toepassing op zaad kunnen de micro-organismen meegroeien met de opkomende wortel en deze zo snel mogelijk koloniseren.
Toepassing van micro-organismen op zaad brengt zijn eigen uitdagingen met zich mee, waarover meer in het volgende artikel.